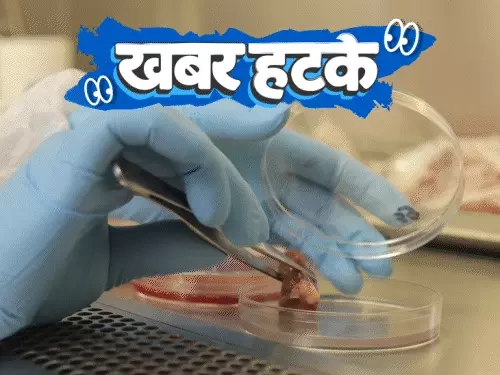
जापानी वैज्ञानिकों ने ऐसी दवा खोजी है, जिससे हर इंसान 100 सालों से ज्यादा जिंदा रह सकेगा

जापानी वैज्ञानिकों ने ऐसी दवा खोजी है, जिससे हर इंसान 100 सालों से ज्यादा जिंदा रह सकेगा। वहीं यूरोप में पेड़ों की पत्तियों से सोना निकल रहा है।

Daily news
जापानी वैज्ञानिकों ने ऐसी दवा खोजी है, जिससे हर इंसान 100 सालों से ज्यादा जिंदा रह सकेगा। वहीं यूरोप में पेड़ों की पत्तियों से सोना निकल रहा है।